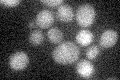
YDR147W
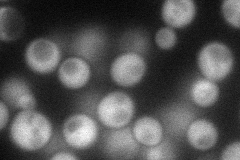
YDR147W
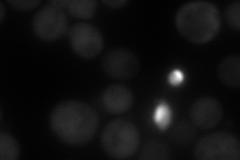
YDR147W
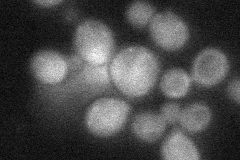
YDR147W
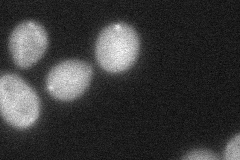
YDR147W

View description
Ethanolamine kinase, primarily responsible for phosphatidylethanolamine synthesis via the CDP-ethanolamine pathway; exhibits some choline kinase activity, thus contributing to phosphatidylcholine synthesis via the CDP-choline pathway
Localization:
Intensity:
Fold change:
Significance:
-
C’ GFP library in SD
below threshold15.07 -
N' NOP1pr-GFP in SD
cytosol65.6822 -
N' TEF2pr-mCherry in SD
cytosol62.3441 -
N' NATIVEpr-GFP in SD
cytosol25.2988 -
N' TEF2pr-VC and Cyto-VN in SD
cytosol,punctate43.4471 -
C’ GFP library in SD+DTT

cytosol17.961.19No -
C’ GFP library in SD+H2O2

cytosol16.731.1No -
C’ GFP library in Starvation Media

cytosol16.421.08No -
C’ GFP library on the background of Pup2-DaMP

below threshold -
C’ GFP library on the background of CCT mutant

below threshold16.4161.08876No
